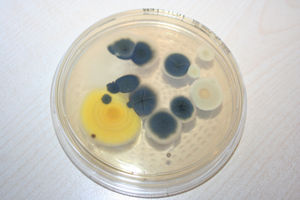
Kauf Einer Gebrauchten Immobilie Schimmel Im Haus

Schimmel In Der Mietwohnung Das Ist Zu Tun Immowelt At

Schimmel Im Keller Bekampfen Das Konnen Sie Tun

Was Tun Bei Feuchtigkeit Im Haus Heimwerker De

Sektion Bern Was Tun Bei Schimmel Im Haus Oder In Der Wohnung

Gruner Schimmel Im Schlafzimmer Was Tun Wohnung Haus Mietrecht

Schimmel In Der Ecke

Schimmel In Der Wohnung Die Rechte Der Mieter Deutsche

Schimmel Im Haus Vermeiden Und Entfernen Tipps Vom Experten Das

Baumentor Der Bauratgeber

Schimmel Im Haus Was Bauherren Und Immobilienkaufer Tun Konnen

Schimmel Im Haus Was Tun R V Blog

Ratgeber Schimmel Im Haus Umweltbundesamt

Schimmel Gutachter Fur Wurzburg Bei Schimmel Im Haus Oder In Der

Schimmel Dauerhaft Im Haus Entfernen Hilfreiche Tipps Und Methoden

Bredstedt Online News Blog Bredstedt Ekc Bredstedt Schimmel

Haufige Fragen Bei Schimmelbefall Umweltbundesamt

Schimmel An Der Aussenwand So Werden Sie Ihn Los

Was Gegen Schimmel Im Haus Zu Tun Ist

Richtig Luften 12 Tipps Schimmel In Der Wohnung Vermeiden Utopia

Schimmel In Der Wohnung Wie Gefahrlich Sind Schimmelflachen

Roland Hilgers Linkedin

Schimmel Im Haus Zum Neuen Jahr

Haufige Fragen Bei Schimmelbefall Umweltbundesamt

Ursachen Und Tipps Gegen Schimmel Im Keller

Osr0dzofxlucbm

Schimmel Trotz Luften Und Heizen Infos Tipps Luftbewusst De

Tipps Mittel Gegen Schimmel Feuchtigkeit In Haus Und Wohnung

Schwamm Im Haus Und Schimmelbefall Was Hilft

Schimmel Im Haus Ursachen Risiken Massnahmen

Schimmel Entfernen Vorbeugen Co2online

Silikonfugen Reinigen Schimmel Von Silikonfuge Entfernen Fugen

Schimmel Im Schlafzimmer Wie Entferne Ich Ihn Wohnen

Luftungsanlage Hilft Schimmel Im Haus Zu Vermeiden Berlin De

Schimmel Im Haus Was Tun Sv Sparkassenversicherung

Feuchter Schimmelkeller Und Jetzt Renovieren De

Dem Pilz Keine Chance Schimmelbekampfung Im Wohnraum Bauen De

Schimmel Im Keller Entfernen Bekampfen Anleitung Philognosie
Kauf Einer Gebrauchten Immobilie Schimmel Im Haus

Schimmel Dauerhaft Im Haus Entfernen Hilfreiche Tipps Und Methoden

Schimmel Im Haus Was Tun Ausarten Alles Uber Installateur

Ab Wann Schimmel Im Haus Schadlich Ist Experten Interview

63 News Von Isotec Gmbh Pressemeldungen 2020 Presseportal

Schimmel In Der Wohnung Das Sind Ihre Rechte Als Mieter

Schimmelimhaus Instagram Posts Gramho Com

Sparkasse Leben Schimmelbefall In Wohnung Und Haus Was Tun

Luften Im Winter So Machen Sie Es Richtig Luftbewusst De

Schimmel Im Schlafzimmer Was Kann Ich Dagegen Tun Schimmel Im

Schimmel Im Haus Meine 3 Tipps Zur Ersten Hilfe Und Beseitigung

Das Infrarot Thermometer Hilft Dabei Schimmel Im Haus Zu

Silikonfugen Reinigen Schimmel Von Silikonfuge Entfernen Fugen

Das Sind Die Ursachen Fur Schimmel Im Haus Energie Fachberater

Schimmel Im Haus Entfernen Und Vorbeugen Liebenswert Magazin

Alles Uber Schimmel In Wohnungen Verbraucherzentrale De

Die Wohnraumluftung Gegen Schimmel Heizung De

Faq Schimmel Vorbeugen So Vermeiden Sie Schimmel In Ihren Raumen

Informationen Was Man Tun Kann Wenn Man Schimmel Im Haus Findet

Welche Rechte Und Pflichten Haben Mieter Bei Schimmel In Ihrer

Schimmel Im Haus Meine 3 Tipps Zur Ersten Hilfe Und Beseitigung

Kauf Einer Gebrauchten Immobilie Schimmel Im Haus

Woher Kommt Im Fruhling Der Schimmel Im Haus Wohnen

Schimmel Auf Feuchten Wanden Im Haus Bas Mauerwerkstrockenlegung

Schwarzer Schimmel Ist Schwarzschimmel Gefahrlich

Schimmel In Der Ecke

Pilzbefall In Der Wohnung Was Sie Gegen Schimmel Tun Konnen

Hohe Luftfeuchtigkeit Was Tun Bei Schimmel Im Haus Wissen

Schimmel Dauerhaft Im Haus Entfernen Hilfreiche Tipps Und Methoden

Richtig Luften Hilft Gegen Schimmel Der Wohnung

Feuchtigkeit In Der Wand Entfernen Holzfenster Pflege Maler

Ratgeber Schimmel Energie Fachberater

Schwarzer Schimmel Am Dachfenster

Wie Sie Den Schimmel In Der Wohnung Bekampfen Welt

Schimmel In Der Wohnung Welche Versicherung Zahlt Ideal

Tuckische Sporen Bei Der Schimmelentfernung Ist Atemschutz

Schimmel Entfernen Das Haus

Schimmel Im Haus Vorbeugen Und Entfernen Ndr De Ratgeber

Sauna Schimmel Das Muss Man Im Schadensfall Beachten

Schimmel Am Fenster Warum Er Entsteht Was Man Tun Kann

Schimmel Im Putz So Entfernen Sie Ihn Erfolgreich Hausgarten Net

Expertentipp Schimmel Im Haus Vorbeugen Und Bekampfen Das

Wenn Luften Nicht Mehr Hilft Was Man Zu Schimmel Wissen Muss N

Tipps Gegen Schimmel Im Bad So Konnen Sie Schimmel Im Badezimmer

Schwarzschimmel So Gefahrlich Ist Der Pilz

Schimmel Im Schlafzimmer Das Haus

Schimmel Im Bad Tipps Zur Pilzbekampfung Stern De

Melinda Tatus Melindatatus Auf Pinterest

Schimmel Entfernen So Werden Sie Den Pilz Fur Immer Los

Schimmel In Der Wohnung Was Ist Zu Tun

Schimmel Im Haus Was Mussen Sie Wissen Bei Westfalia Versand

Dunkle Seite Des Winters Schimmel Im Haus Vorbeugen Wohnen

Falls Du Probleme Mit Schimmel Im Haus Haben Solltest Und Du Nicht

Schimmel Entfernung Richtig Schnell Einfach Informiert

Schimmel Im Haus Sachverstandige Zeigt Wo Und Warum

Vortrag Schimmel Im Haus Was Tun Donnerwetter De

Schimmel Im Haus Was Tun Sv Sparkassenversicherung

Schimmel Im Haus Das Sollten Sie Auf Keinen Fall Tun Energie

ᐅ Schimmel In Der Wohnung Was Tun Nutzliche Tipps Uceh

Schimmel An Der Wand Entfernen Ursachen Tipps Tests

Schimmelflecken Im Haus Das Ist Zu Tun Wohnen

